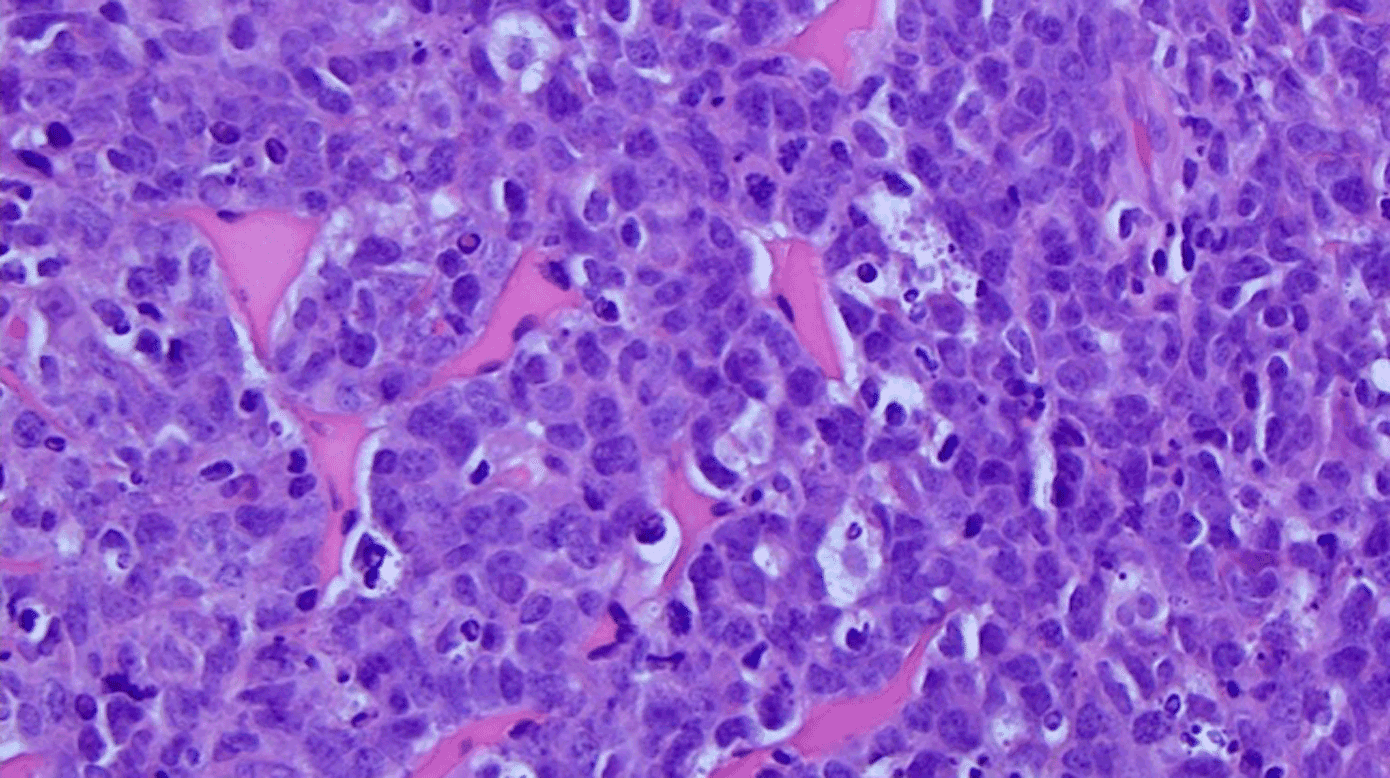
cover

Burkitts lymfom hos pige med perifer facialisparese og mammaeinvolvering

Emil Kudahl Christensen & Christina Friis Jensen
Burkitts lymfom (BL) er en sjælden højmalign undertype af B-celle-non-Hodgkin-lymfom (NHL) karakteriseret ved en yderst høj proliferationsrate med en fordobling af tumorbyrden på blot 24 t. [1]. Epidemiologisk skelnes mellem tre varianter: den endemiske (Afrika-, Epstein-Barr-virus- og malariaassocierede), den immundefektassocierede (oftest hiv) og den sporadiske, som dominerer i Vesten og i op mod 30% er Epstein-Barr-virus-associeret [1, 2].
I Vesten udgør sporadisk BL kun 1-2% af NHL hos voksne, men op mod 30% hos børn og unge [1]. Typiske debutmanifestationer er fra ekstranodalt lymfoidt væv, især gastrointestinalkanalen, med abdominal udfyldning, mavesmerter, kvalme og ændret afføringsmønster. Klassiske B-symptomer er hyppige, og knoglemarvsinvolvering ses hos op mod 35%, hvilket kan manifestere sig biokemisk med anæmi, trombocytopeni og leukopeni.
I nogle tilfælde forekommer en leukæmiseret fase med blaster i perifert blod, mens parakliniske fund typisk viser forhøjet laktatdehydrogenaseniveau og hyperurikæmi. Diagnosen bekræftes ved biopsi med påvisning af MYC-translokation [1, 3].
Sjældnere manifestationer omfatter nodal lymfadenopati, perifer facialisparese og mammaeinvolvering hos piger [1, 3, 4].
En tidligere rask 17-årig pige udviklede en kortvarig (ca. 15 min) perifer facialisparese, initialt tolket som migræne. En uge senere recidiverede paresen og var nu vedvarende. Hun blev vurderet af en privatpraktiserende ØNH-læge, som igangsatte behandling med prednisolon 50 mg × 1 dgl. i 10 dage og henviste samme dag til akutmodtagelse for børn og unge.
Ved ankomsten var hun velbefindende fraset facialisparesen og beskrev forbigående kæbesmerter.
Prøve via lumbalpunktur var upåfaldende. Blodprøver viste let anæmi (hæmoglobin (hgb)-niveau 6,0 mmol/l) og leukopeni (3,8 × 109 mmol/l). Forløbet blev vurderet som Bells parese, og hun blev udskrevet med planlagt kontrol.
På dag 11 udviklede hun øresmerter og diffuse knoglesmerter, som blev behandlet symptomatisk.
Tre uger efter debut havde hun feber, træthed, abdominale smerter og tiltagende bilateral mammaeforstørrelse. Facialisparesen var uændret trods fuldført prednisolonbehandling. Ved en objektiv undersøgelse fandtes store, ømme udfyldninger i begge mammae.
Blodprøver viste progredierende anæmi (hgb 5,3 mmol/l), let trombocytopeni (114 × 109/l), forhøjet laktatdehydrogenaseniveau (3.624 IU/l), let alaninaminotransferaseforhøjelse (86 IU/l), forhøjet ferritinniveau (3.674 µg/l) og forhøjet CRP-niveau (141 mg/l). Serologisk test af Epstein-Barr-virus-IgG havde positivt udfald. Patienten angav desuden betydelig nattesved gennem 4-5 uger samt vægttab på 5 kg.
Perifert blodudstryg og flowcytometri, biopsi fra glandler samt PET-CT påviste leukæmiseret BL stadie IV med knoglemarvsinvolvering og ekstranodal affektion i mammae og ovarier (Figur 1 A). En MR-skanning viste let opladning langs højresidig n. facialis (Figur 1 B). Histologiske tests viste klassisk BL med Ki-67 på 100% og MYC-translokation (Figur 1 C).
Hos børn og unge er perifer facialisparese oftest en benign og idiopatisk tilstand. Malignitet som årsag er yderst sjælden, men bør overvejes ved atypiske forløb. I dette tilfælde blev prednisolon påbegyndt i overensstemmelse med gældende anbefalinger, selv om evidensen for børn og unge er begrænset [5]. En potentiel ulempe ved rutinemæssig prednisolonbehandling er, at delvis symptomlindring uden reel regression kan forsinke erkendelsen af underliggende malign sygdom.
Mistanken om malignitet bør derfor skærpes ved atypisk udvikling, herunder særligt ved recidiv af en initialt kortvarig parese, mangelfuld bedring af en persisterende parese trods fuld prednisolonbehandling og ved samtidige lette cytopenier eller knoglesmerter. Ledsagende B-symptomer og nytilkomne organspecifikke symptomer, som f.eks. abdominalsmerter eller mammaeforstørrelse, bør ligeledes give anledning til fornyet vurdering.
Facialisparese ved Burkitts lymfom
I en opgørelse af 53 børn med BL havde 19% forbigående perifer facialisparese som led i debutbilledet . Mekanismerne omfatter leptomeningeal spredning eller direkte nerveinvolvering, hvilket understøttes af den beskedne MR-opladning langs n. facialis hos vores patient [2].
Mammaeaffektion er sjælden ved sporadisk BL og typisk sekundært til dissemineret sygdom. Hos piger og unge kvinder kan det hormonelt aktive og vaskulariserede mammavæv være særligt modtageligt for lymfocytinfiltration, men væksten skal fortsat forstås i lyset af BL’s i forvejen ekstremt høje proliferationsrate [3].
Sygehistorien illustrerer, at selv om facialisparese oftest er benign, bør et atypisk forløb eller ledsagende systemiske fund føre til fornyet vurdering og supplerende udredning.
Korrespondance Emil Kudahl Christensen. E-mail: emil.c@rn.dk
Antaget 3. februar 2026
Publiceret på ugeskriftet.dk 27. april 2026
Interessekonflikter ingen. Alle forfattere har indsendt ICMJE Form for Disclosure of Potential Conflicts of Interest. Disse er tilgængelige sammen med artiklen på ugeskriftet.dk
Taksigelser Marianne Schmidt Ettrup, Patologiafdelingen, Aalborg Universitetshospital, takkes for beskrivelse af histologi og illustration af HE-snit. Graziella Andersen, Radiologisk Afdeling, Aalborg Universitetshospital, takkes for MR-billeder og radiologisk beskrivelse. Trine Borup Andersen, Nuklearmedicinsk Afdeling, Aalborg Universitetshospital, takkes for PET-CT-billede og radiologisk beskrivelse
Referencer findes i artiklen publiceret på ugeskriftet.dk
Artikelreference Ugeskr Læger 2026;188:V10250787
doi 10.61409/V10250787
Open Access under Creative Commons License CC BY-NC-ND 4.0
Burkitt lymphoma (BL) is a rare, aggressive B-cell non-Hodgkin lymphoma with rapid proliferation. Typical manifestations include abdominal disease, B-symptoms and bone marrow infiltration, while rare presentations may include nodal disease, facial palsy and breast involvement. This case report presents a 17-year-old girl with sporadic BL who developed peripheral facial palsy and rapid bilateral breast enlargement. This case highlights the importance of systematic follow-up after facial palsy in young patients and attention to associated symptoms and biochemical abnormalities suggestive of malignancy.